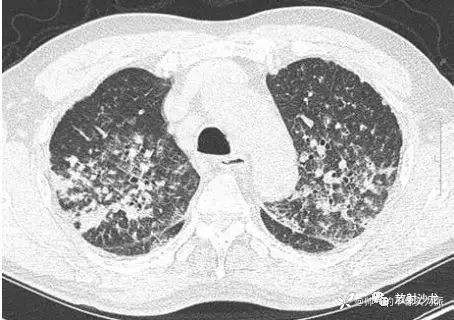
img
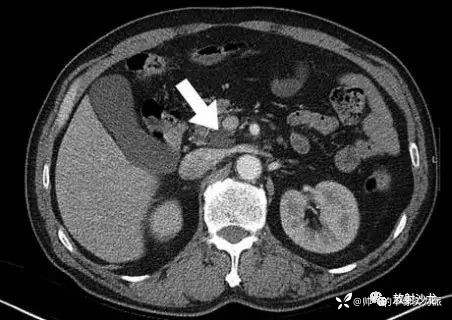
img

疑难病例分享:这个呼吸困难的患者来找你就诊,你能诊断出来吗

61岁男性呼吸困难,
临床病史:1例61岁的男性因呼吸困难到门诊就诊,主诉干咳、轻度呼吸困难伴寒战和盗汗2周。
既往史:患者有5年的2型糖尿病史;30余年的吸烟史,现已戒烟10年。
体格检查:患者的生命体征如下:BP103/67mmHg ,心率103次/min ,呼吸频率22次/min,体温36.7℃。体检未见明显异常。
实验室检查
全血细胞计数、常规生化、血清淀粉酶和脂肪酶以及心肌酶均正常,血糖145mg/dL。血气分析示pH7.37,氧分压61mmHg,二氧化碳分压36.8mmHg,HCO3-20.9mmol/L,血氧饱和度91% (鼻导管吸氧中,6 L/min)。
影像学和支气管镜检查
胸部平片见图1。胸部CT扫描显示多发结节、双侧气腔实变和磨玻璃征(图2),多发结节都分布在淋巴组织周围。腹部CT平扫显示胰头处有一个直径2 cm 的低密度团块阴影(图3)。对患者行气管镜检查以除外恶性疾病或结核,术中未见支气管内病变。对支气管镜获取的样本进行了细胞学检测、抗酸染色和TB聚合酶链反应,结果均为阴性;支气管肺泡灌洗液培养也为阴性。多重聚合酶联反应未检测到A 型和B 型流感病毒、1~3型副流感病毒、呼吸道合胞病毒、腺病毒、鼻病毒以及间质肺病毒。

图1 胸片显示两肺多发边界不清的结节影
图2 胸部CT示多发结节、双侧气腔实变以及磨玻璃征
图3 腹部CT示胰头有一直径2 cm 的低密度团块阴影(箭头处)
肺活检样本
患者随后接受了电视胸腔镜肺活检术。活检样本见胸膜下纤维化结节,其中见淋巴浆细胞浸润(图4),周围肺实质见片状实变区, 其间有淋巴浆细胞浸润。免疫组化染色后结节内见大量IgG4阳性浆细胞,且IgG4/IgG>1.5。患者血清中IgG4 水平为1.85g/L(正常范围为0.11~1.59g/L),免疫电泳示IgG比例下降。

图4 肺活检样本
A:电视胸腔镜活检肺组织显示胸膜下结节状病变,伴中央结节纤维化(星标处)(苏木精和曙红染色,原始放大倍数×40);
B:高倍放大的矩形病变显示淋巴细胞和浆细胞浸润(苏木精和曙红染色,原始放大倍数×400);C:免疫组化染色示IgG4表达高于IgG (原始放大倍数×200)。
诊断:IgG4相关硬化性疾病导致的急性呼吸衰竭。
IgG4相关硬化性疾病(ISD)是一种系统性疾病,表现为IgG4阳性浆细胞和T淋巴细胞在多个器官浸润,伴组织纤维化和阻塞性静脉炎。ISD首次报道于自身免疫性胰腺炎,现在发现ISD 可累及多个器官,如肝脏、胆管、唾液腺和泪腺、肾脏、腹膜后、主动脉和肺等。ISD的发生与血清IgG4的升高有关,好发于60~65岁男性。
ISD 的临床表现缺乏特异性,主要症状与受累及的器官相关,全身症状如发热、体重减轻等较少见。ISD的组织病理学特点为弥漫性淋巴浆细胞浸润、纤维组织增生、嗜酸性粒细胞浸润和闭塞性脉管炎。纤维炎症反应区免疫组化染色显示富含IgG4阳性浆细胞,IgG4/IgG阳性浆细胞的比率>30%。多数患者的血清IgG4水平升高,但IgG4正常不能排除该病。ISD的发病机制尚不清楚,研究表明该病与免疫相关,且多种免疫细胞及细胞因子参与了IgG4阳性浆细胞浸润和纤维化,如Th2 型细胞因子、Treg、IL-10和TGF-β等。
ISD 对糖皮质类固醇激素治疗有效,首选口服泼尼松,但其确切剂量尚未明确。剂量选择视具体病情而定,最大起始剂量不超过1 mg·kg-1·d-1。激素治疗有效为自身免疫性胰腺炎的诊断标准之一。激素能有效改善ISD 临床与影像学表现,降低血清IgG4水平。ISD的诊断较为复杂,需综合临床、生化、影像、病理学表现及对激素治疗的反应性来明确诊断。
肺部受累是ISD 患者胸内症状的一种表现,胸内病变见于胰腺炎或其他肺外病变的任何时期。最常见的呼吸系统症状是咳嗽、呼吸困难和胸痛,少数患者可无症状。胸片表现为多发圆形结节、肺泡间质疾病、气管支气管狭窄、胸膜结节或胸腔积液。组织活检有助于鉴别有相似影像学表现的疾病,如肺癌、淋巴瘤、结节病等。活检标本表现为淋巴浆细胞浸润,免疫组化染色见IgG4的阳性淋巴浆细胞浸润和高比率IgG4/IgG阳性浆细胞有助于ISD的准确诊断。激素治疗对有胸内和胸外表现的ISD患者总体有效,一般1~2wk内即可见效,之后激素减量。
最初我们依据患者影像学表现考虑为疑似肺炎伴结核或转移性肺癌,行支气管镜检查,同时对患者进行经验性治疗,给予头孢曲松 (2g/d)和阿奇霉素(500mg/d)。支气管肺泡灌洗检查结果阴性,抗生素治疗10d后复查胸片未见明显改变。以上基本排除最初的诊断。随后采用电视胸腔镜肺活检术对病灶处进行组织病理学检查,活检标本内可见肺实质和胸膜下结节中淋巴浆细胞浸润明显,考虑ISD 的可能性大。进一步的免疫组化染色显示IgG4阳性浆细胞分布广泛,IgG4/IgG阳性比率偏高,血清IgG4水平升高。尽管患者腹部CT平扫显示有胰头肿块,但无其他系统症状,血清淀粉酶和脂肪酶均在正常水平,故未对该肿块进行活检。综合以上分析,诊断该患者为ISD引起的急性呼吸衰竭。
临床过程:
患者开始口服泼尼松治疗,初始剂量为0.5mg·kg-1·d-1,治疗1wk后,患者的呼吸系统症状迅速缓解,肺部多发结节也得到明显吸收(图5) ;2wk后泼尼松剂量减至0.25mg·kg-1·d-1。现该患者在定期随访中。

图5 2wk治疗后,复查CT示多发结节得到明显吸收
临床小贴士
1 肺部多发小结节的鉴别诊断包括结节病、结核和转移性肺癌,也要考虑IgG4硬化症。
2 IgG4 硬化症通常表现为无症状性团块或结节,IgG4相关硬化症可表现为急性低氧性呼吸衰竭。
3 IgG4 相关硬化性肺病可有腹部的病理表现,如硬化性胆管炎和胰腺炎等。怀疑ISD 时可行腹部CT检查以协助诊断。
4 糖皮质类固醇激素治疗能迅速缓解临床症状及结节消退。